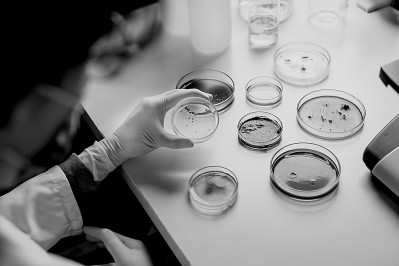

在广袤的田野上,每一抔泥土都隐藏着一个微观的奇妙世界——数量庞大、种类繁多的微生物。虽肉眼不可见,它们却是农作物的隐形“守护者”,在农业领域扮演着极为关键的角色。近年来,微生物研究进入了一个全新的发展阶段,尤其是在土壤微生物群落、植物与微生物相互作用等方面的探索,为现代农业发展提供了重要支撑。在全球农业面临高效生产与环境保护双重压力的背景下,微生物正在改变传统农业的生产模式,并为解决诸多难题提供新思路。
搞清作物的“第二基因组”
微生物,是一类体型微小、结构简单的生物,包括细菌、真菌、病毒等。它们广泛存在于土壤、水体、空气中,当然,也包括农作物的根际土壤。这些微生物数量惊人,1克土壤中就可能含有数十亿个微生物细胞。它们编码的基因组信息约为植物自身的数十倍,被称为作物“第二基因组”。
长期以来,人类对土壤微生物的认识停留在“黑箱”状态——大量微生物因难以在实验室培养,因此无法获取其功能特性,更难在农业生产中加以利用。然而,随着技术的不断创新,高通量的微生物分离培养已成为可能,越来越多的微生物能被进一步研究及挖掘,它们自带的遗传信息也逐渐被揭示,作物“第二基因组图谱”呼之欲出。
那么,从复杂的环境中获取这些微生物资源需要解决哪些问题呢?主要是两大挑战:一是如何从植物微生物群落中获得大量可培养的单一菌株;二是如何对这些菌株进行筛选并准确地进行物种鉴定?
如今,这两大挑战都有了解决办法。简单来说,第一个问题的解决方法是基于梯度稀释的原理,利用多种不同的细菌培养基对根际微生物群落进行稀释,分离出大量可培养的单一细菌悬液。每个分离出来的细菌悬液都会被赋予一个标签,以便后续区分和追踪。解决第二个问题则要采用高通量测序技术,获取所有细菌悬液的对应序列标签和物种信息。通过追踪这些标签,可以筛选出一些独特且有潜力的菌株,以进一步进行基因组测序,绘制其完整的基因组信息。
经过近10年的积累,我国科研团队不断接力,已经完成了涵盖水稻、小麦、玉米等主粮作物及番茄、苜蓿等十余种经济作物的根系细菌资源库,并配套详细的基因组图谱。这些资源不仅为本领域研究提供丰富的菌株基础,更为将来发展个性化施肥、定制型微生物菌剂等农业新技术打下了坚实基础。在农田管理中,传统“靠经验、靠惯例”的施肥施药方式,正逐步被“看基因、看微生物”的科学化决策所取代。
农业生产的多功能伙伴
微生物在农业中的作用,远比我们想象的强大得多。
微生物是农作物的“营养师”,通过分解土壤中的植物难以直接利用的养分形式,如有机物质、氧化物或难溶性盐类,将其转化为离子态,提高植物对氮、磷、钾、铁等营养元素的吸收。同时,微生物还能与植物根系形成共生关系,这些微生物就像是蚁群中的工蚁,将更多的营养持续不断地输送给蚁后(植物),帮助植物更高效地吸收这些养分。例如,根瘤菌与豆科植物共生,能将大气中的氮气转化为植物可利用的氮素,大大提高了土壤的肥力;水稻的两个亚种籼稻和粳稻在氮利用效率上存在显著差异,籼稻根系富集更多与氮循环相关的微生物类群,这些微生物帮助水稻利用土壤中的有机氮,可能是籼稻氮肥利用效率高于粳稻的重要原因之一。
除了帮助植物吸收养分,微生物还能增强植物对逆境的耐受性。在干旱、盐碱、高温等恶劣环境下,一些特定的微生物能够帮助植物调节自身的生理代谢,提高植物的抗逆能力,使其更好地适应环境变化。此外,微生物还能成为植物“卫士”,帮助植物抵御病害的侵袭,如赤霉病、青枯病、根腐病等常见农业病害。它们可以通过竞争营养、产生抗菌物质等方式,抑制病原菌的生长和繁殖,从而减少病害的发生,增强作物对恶劣环境的适应能力,为农业生产应对日益频繁的极端天气提供有效策略。或许在不远的将来,这些菌株可以为作物加上“环境保险”,提高作物在不可控环境中的自保能力,以减少农业生产损失。
在提升作物品质和产量方面,微生物也发挥着出乎意料的作用。以往我们观察到的一些作物优质表型,可能在很大程度上源于微生物的作用。例如,高油大豆品种的根际富含大量Massilia细菌,这些细菌通过激活大豆的相关遗传通路,促进种子中油脂的积累,从而改善大豆的品质。这可能是该品种在优良遗传基因之外的另一重要原因。此外,某些微生物分泌的小分子信号能够直接影响植物的生长发育,从而提高作物的产量。例如,水稻根际属于Exiguobacterium的菌株可以在自然田间调控水稻的分蘖数量,其合成的环二肽cyclo(Leu-Pro)能够作用于水稻的激素受体,模拟作物内源信号,从而调控水稻的分蘖表型。这些发现为作物品质改良及单位面积产量提升,提供了一种新思路,即通过调节微生物组来优化已有品种的作物性状,而非依赖传统的长周期育种策略。
农业可持续发展的新方向
随着科技的不断进步,我们对微生物的认识也在不断深入,它们在农业生产中大有可为,为相关产业带来更广阔的发展空间。
一方面,我们可以利用微生物的功能特性,开发出更加精准、稳定、高效、环保的农业微生物菌剂。通过整合多种功能菌的特性,开发出功能多元化的复合菌剂,菌剂中的微生物可以相互协作,在田间环境进行稳定的功能输出,综合促进作物的生长。
此外,根据不同作物或同一作物不同发育时期的需求,有针对性地补充有益微生物,提高土壤肥力,增强植物抗逆性,调控生长发育进程,实现农业生产高产、稳产、优质的目标。与传统的“化肥+农药”的生产模式不同,有益微生物的应用在提升作物产量和品质的同时,显著减少对环境的负面影响。这种方法通过更精细的资源管理和更小的环境代价,推动农业的绿色、可持续发展。
另一方面,我们可以通过研究微生物与植物之间的相互作用,揭示植物主动塑造根际微生态的机制。例如,植物根部会释放一些特殊的次生代谢物,如三萜、香豆素等,这些化合物具有“选择性喂养”作用,能促进有益菌群生长,抑制潜在有害菌的定植。我们可以通过引导植物自身的代谢路径,间接调控其微生物组,实现更加安全、无污染的农业生产。
此外,微生物在农业病害防控方面也有着巨大潜力。通过挖掘微生物中的“暗物质”,我们可以发现更多具有防病、抗虫功能的有益化合物,为农业病害防控提供新的思路和方法。例如,一种能显著抑制小麦赤霉病的有益菌株可以分泌Herbicolin A,这种物质能够精准破坏病原真菌的细胞膜,表现出强大的防病潜力。这些成果不仅拓展了农业病害防控的路径,也为发展微生物新药、农业合成生物技术提供了“原材料库”,为微生物在农业中的应用开辟了新的领域。
在全球范围内,随着农业绿色转型的加速,微生物技术的研发和应用已逐渐成为农业科技创新的重要驱动力。笔者团队通过十多年持续攻关,围绕“第二基因组”的资源建设、功能解析与应用转化,系统推进了我国根际微生物研究体系化进程,并为国家农业绿色发展和种业振兴战略提供了重要科技支撑。
研究这些微生物,是希望让种地更科学、施肥更精准、病虫害更少,让农业真正实现高效可持续。在全球高度关注绿色替代和种源创新的背景下,微生物研究正成为农业科技新的增长极。随着国家对绿色农业、减肥增效、种业突破的持续布局,作物“第二基因组”的研究不仅是科学家的兴趣,更是国家的战略需要。
从微观根际到广袤田野,从实验室数据到亩产提升,这项研究正在改变农业的思维方式,也正在改变你我餐桌上那碗米饭的来源方式。
(作者:白洋,系北京大学生命科学学院研究员)



 上一版
上一版